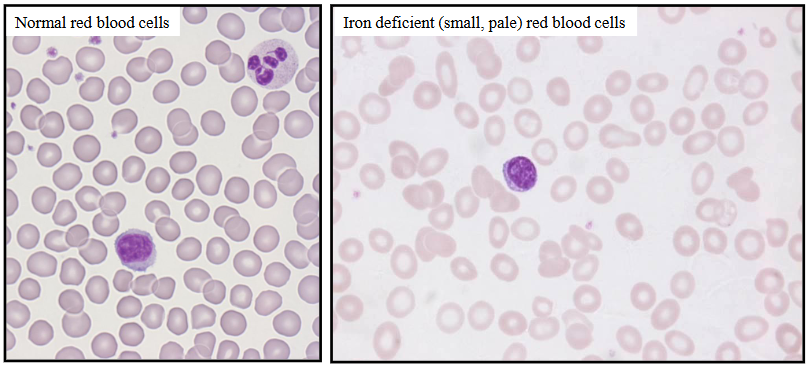
<p>Haematology of Iron Deficiency Anaemia</p>
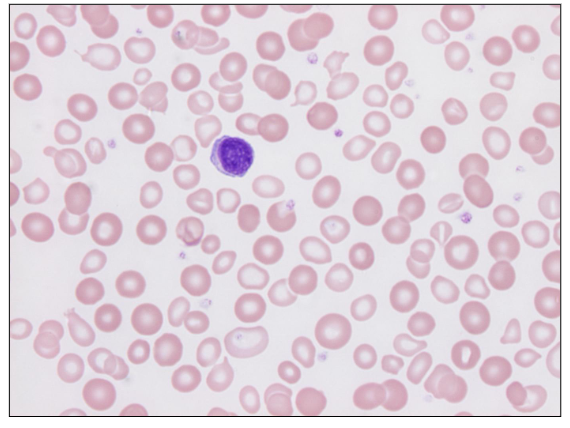
<p>- Partially treated iron deficiency</p><p>- both small pale and cells (residual iron deficient cells) and normal RBC</p>
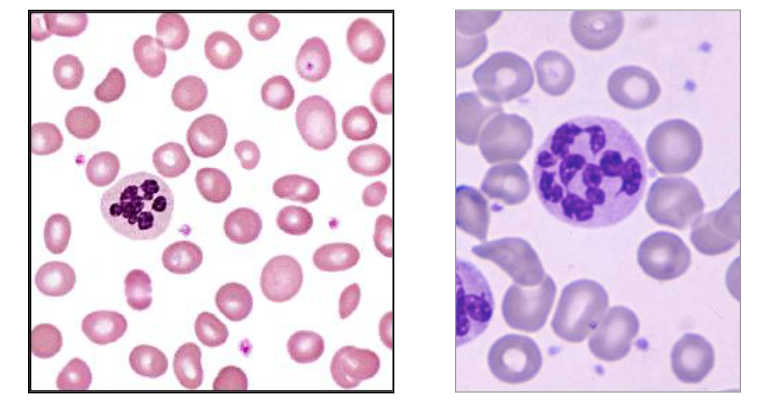
<p>Megaloblastic Anaemia</p>

(L4) IMED2002 - Anaemia 1 - Reduced RBC Production
1/47
There's no tags or description
Looks like no tags are added yet.
Name | Mastery | Learn | Test | Matching | Spaced | Call with Kai |
|---|
No analytics yet
Send a link to your students to track their progress
48 Terms

Causes of Anaemia - reduced bone marrow production
- Primary: bone marrow failure or dysfunction
- Secondary: insufficient nutrients iron, folate, vitamin B12, EPO

Iron
- important mineral in the human body
- exists in all cells in various amount
- body iron stores: 4 gm
body iron at different sites:
- RBC: = 70% of body Fe (in Hb)
- one gram Hb = 3.5mg iron (2.5g Fe in RBC [Hb])
.
STORAGE IRON (FERRITIN): 30% of body Fe
MYOGLOBIN (Fe in muscle): 4% body iron
ENZYMES (cytochrome system in mitochondria)
Source of Body Iron
- Daily Fe intake = 10-20mg/day
- 10% intake is absorbed (1mg/day)
.
Iron absorption requires acidic environment
- Vitamin C: increases iron absorption
- Coffee and tea: inhibit iron absorption
- Fe in human milk more easily absorbed than cows
.
Daily Iron requirements:
- males and non-menstruating females: 1mg/day
- menstruating females: 2mg/day

Body Iron Distribution
- normal iron content is around 4000mg
- Red blood cells: 2500mg
- Myoglobin: 300mg
- Enzymes: 200mg
- Storage iron: 1000mg (Liver, spleen (reticulo-endothelial system) and bone marrow)


Iron Balance
LOSS:
- Skin, gut, sweat - 1mg/day
- Menses - 1mg/day
GAIN:
- Diet - 10% of 10mg/day


Iron Cycle
- absorbed iron transported to marrow bound to transferrin
- iron utilised in erythropoiesis
- released iron taken up by macrophages
- Excess iron is stored in macrophages and liver as ferritin


Where in the gastrointestinal tract is iron maximally absorbed
Iron is maximally absorbed in the duodenum and the proximal (upper) jejunum

Iron Deficiency Anaemia is common
- WHO estimates >30% of the world's population is anaemic
Global prevalence of anaemia:
- males: 10%
- non-pregnant females: 30%
- pregnant females: 40%
.
- mainly due to iron deficiency
Iron Deficiency: the causes
REDUCED INTAKE:
- poor intake
- poor absorption
.
INCREASED USAGE
- blood loss
- increased utilisation
Causes of Iron Deficiency
REDUCED INTAKE:
- rare in developed world
- commonest form of anaemia in pediatrics
.
POOR IRON ABSORPTION/MALABSORPTION:
- stomach or bowel: gastrectomy; coeliac disease
.
CHRONIC BLOOD LOSS (loss of iron)
- GI: ulcers, carcinoma, varices, haemorrhoids
- Uterine bleeding (menorrhagia)
.
INCREASED IRON UTILISATION:
- Neonates; puberty; pregnancy (3mg/day)
- Tissue and organ growth

Iron Deficiency - occurs in stages
- Negative iron balance - reduced iron stores, normal RBC iron, no anaemia
- iron deficient erythropoiesis - reduced iron stores, mildly reduced RBC iron, no anaemia
- iron deficiency anaemia - reduced iron stores, reduced RBC iron and anaemia


Causes of Iron Deficiency by Age
DIAGRAM ON SLIDE 16

Haematology of Iron Deficiency Anaemia
- Anaemia (low Hb); reduced MCV (<80 fl)
- blood film: hypochromic (pale) microcytic (small) red blood cells, pencil-shaped cells and elliptocytes


Lab Features of Iron Deficiency Anaemia
- mild thrombocytosis (increased platelet count)
- reduced reticulocyte count (insufficient new RBC being made in BM)
.
BONE MARROW:
- reduced erythropoiesis
- reduced iron stores (blue stain for iron)
.
- person on the right has no blue staining, meaning there is no iron in storage

Laboratory Measures of Iron Status
SERUM IRON:
- Highly variable. Not useful to assess iron stores
.
SERUM TRANSFERRIN (Tf):
- measure of iron transporter
.
TRANSFERRIN SATURATION:
- % of iron transporter occupied by iron
.
SERUM FERRITIN:
- reflects body iron stores
Laboratory Measures of Iron Deficiency
- SERUM IRON: Reduced
- SERUM TRANSFERRIN: Increased
- TRANSFERRIN SATURATION: Reduced
- SERUM FERRITIN: Reduced
Establishing the Cause of Iron Deficiency
- Intake: dietary history
- Absorption: test for coeliac disease
- Blood loss (gastrointestinal and uterine) (endoscopy and colonoscopy and pelvic examination)
- Increased utilisation
Management of Iron Deficiency
- Determine and treat the underlying cause:
.
Iron replacement therapy
- oral (tablets or syrup)
- intravenous
- intramuscular (rare)
- duration: to normalise Hb and ferritin (stores)
- Response: increase in Hb; reticulocytosis
.
- blood transfusion: rarely required

Dimorphic Blood Film
- Partially treated iron deficiency
- both small pale and cells (residual iron deficient cells) and normal RBC
Other Essential Nutrients: Vitamin B12 and Folic Acid
- both are required for DNA production
- required for nuclear maturation
- deficiencies cause reduced red cell production
- Abnormal "ineffective: erythropoiesis, called "megaloblastic"
- deficiencies result in anaemia (macrocytic) - high mean cell volume (MCV)
2) Vitamin B12
- complex molecule (cyanocobalamin)
Dietary source (animal products)
- meat, fish, eggs, milk, butter
- absent from vegetables, cereals, fruit
.
- Daily requirements = 0.5-1 microgram/day
- Western diet contains 10-15 micrograms/day (50% absorbed)
- Body stores 2-5mg (mainly liver) (sufficient for 10 years without further supply)
- Deficient intake may take years to manifest
Vitamin B12 (cobalamin)
- essential cofactor in DNA and cell metabolism; methylation in DNA and fatty acid synthesis
.
WHY DO WE NEED VITAMIN B12?
1. Conversion of Homocysteine to Methionine:
- important in methylation of DNA, RNA and proteins
2. Convert Methylmalonyl CoA to Succinyl CoA
- Part of the Kreb's cycle
- Important in fatty acid breakdown and energy production (ATP in mitochondria)
.
- bone marrow is the most rapidly replicating organ in the body (important to know)

How is Vitamin B12 absorbed?
- from mouth - stomach - small bowel (ileum)
- Dietary Vit B12 combines with intrinsic factor (IF)
- IF is secreted by parietal cells in the stomach
- IF - Vitamin B12 complex travels through small bowel
- attaches to receptors in terminal ileum
- Vitamin B12 is absorbed
.
- Absorbed Vitamin B12 attaches to transcobalamin II
- Carries Vit B12 in plasma to the liver, BM, tissues
- most B12 in plasma is attached to another B12 binding protein (transcobalamin I) and is functionally inactive

Causes of Vitamin B12 Deficiency
DIET: Inadequate Intake
- Vegans: no animal products in diet
- Infants born to B12-deficient mothers and breastfed
- Malnutrition, famine, poverty
.
MALABSORPTION:
- Gastric Issues: pernicious anaemia (IF); gastrectomy
- Intestinal causes: defects of the ileum (resected; Crohn's disease); Bacterial overgrowth
- Long term nitrous oxide exposure

Clinical Features of Vit B12 Deficiency
- Asymptomatic; incidental finding
- Gradual onset anaemia
- Mild jaundice (ineffective erythropoiesis due to lack of B12)
.
NEUROPATHY:
- Tingling of the feet; difficulty walking
- Subacute combined degeneration of the spinal cord
- neurodegenerative condition
- Demyelination of the dorsal (posterior) and lateral spinal column


Pernicious Anaemia
- Commonest cause of Vitamin B12 Deficiency
- Auto-immune disease (family history; blood group A)
- auto-antibodies to parietal cells or intrinsic factor interfere with formation IF-B12 complex and B12 absorption
- Females > Males; greying hair
- Anaemia with "lemon yellow" tint
- Macrocytic anaemia (MCV > 100 >110 fL)
- Low Vitamin b12
- Rx: intra-muscular vitamin B12

Vitamin B12 and Vegetarianism
- Vegetarians: unlikely to vitamin B12 deficiency (eat cheese, drink milk)
.
VEGANS: can become vitamin B12 deficient
- Do not eat animal derived products
- Generally well-informed and supplement their diet

Nitrous Oxide and Vitamin B12
- anaesthetic (>150 years) and laughing gas
- NO binds irreversibly to and inactivates Vit B12
- Repetitive or heavy use over extended time causes anaemia and neurotoxicity secondary to Vit B12 deficiency
- Demyelination of dorsal columns leads to subacute combined degeneration of the spinal cord
- "Recreational" use increasing; admissions to ED
- Rx: stop nitrous oxide; Vit B12 (hydroxycobalamin)

Alcohol and Vitamin B12
- consumption of alcohol reduces B12 absorption by 5%
- In alcoholic liver disease there is deficiency of vitamin B1, vitamin B2 and vitamin B6
.
THE CAUSES INCLUDE:
- inadequate dietary intake
- increased use of vitamin B
- decreased storage in liver
- reduced intestinal absorption by ethanol
- abnormal metabolism of the vitamins
Lab Features of B12 Deficiency
BLOOD COUNT AND FILM:
- Macrocytic anaemia (high MCV); oval macrocytes
- Hypersegmented neutrophils
- mild reduction in leucocytes and platelets
.
BIOCHEMISTRY:
- Low serum Vitamin b12
- HoloTransCobalamin assay: measures active B12
- Normal serum folate; raised bilirubin and LDH
.
BONE MARROW:
- megaloblastic (ineffective) erythropoiesis
Treatment Vitamin B12 Deficiency
1000 micrograms hydroxocobalamin IM
- 3x per week for 2 weeks (6 doses)
- Then, 1000 microgram hydroxycobalamin every 3 months for life (unless deficiency is corrected)
.
Large doses of oral vitamin B12 can be given:
- 1-2 mg daily
- Less reliable than IM (esp. for pernicious anaemia)
Where in the gastrointestinal tract is B12 maximally absorbed
Vitamin B12 (cobalamin) is maximally absorbed in the terminal ileum, which is the final section of the small intestine
3) Folate (or Folic Acid)
- Folate: water-soluble naturally occuring B group vitamin (B9)
- Folates present in most foods, especialy: green leafy vegetables, fruits, liver. Folic acid is added to bread, flour, cereals, pasta
- normal diet contains 250-500 micrograms (50% absorbed)
- daily adult requirements approx 100 micrograms
- body stores 5-10mg; sufficient for 3-4 months
- absorbed in upper gastrointestinal tract

Folate Metabolism
- Required for synthesis of DNA (purines; pyrimidines)
- Required for normal maturation of RBC and WBC
- Linked with Vitamin B12 metabolism
- Deficiency: megaloblastic anaemia; neuropathies

Causes of Folate Deficiency
- Diet: reduced folate intake
- Poor absorption
Increased folate requirements: cell turnover
- physiological: pregnancy; lactation; prematurity
- Pathological: haemolytic anaemia; inflammatory conditions; exfoliative dermatitis
- Excess folate loss: dialysis (protein bound)
- Drugs: anti-convulsants
- Other: alcoholism
Investigation of Folate Deficiency
History of clinical features:
- Diet history, drug history, alcohol intake
- Gradual onset of anaemia
- Mild jaundice (ineffective haemopoiesis)
.
Laboratory investigations:
Serum folate: low
Red cell folate: low
Serum Vitamin B12: normal
Treatment of Folate Deficiency
- Folic acid: 5mg per day for a few months
- Correct the anaemia
- Decide whether ongoing folic acid is required: depends on the underlying cause
- dietary advice

Summary: Requirements and Stores
DIAGRAM ON SLIDE 48

Where in the gastrointestinal tract is folic acid maximally absorbed
Folic acid (vitamin B9) is maximally absorbed in the proximal small intestine, specifically within the duodenum and the jejunum
4) Megaloblastic Anaemia
- Due to Vitamin B12 or folate deficiency
- Impaired DNA synthesis of all cells
- Large RBC precursors ("megaloblasts") in BM
- Macrocytic Anaemia (oval): MCV > 100 > 115 fL
- hypersegmented neutrophils
- Hypercellular bone marrow (failed "ineffective" erythropoiesis)
- Reduced serum Vitamin B12 or RBC folate
- Causes as described above
Megaloblastic Anaemia
- Vitamin B12 or Folate Deficiency
Blood: Oval macrocytes and hypersegmented neutrophils:


Bone Marrow: Megaloblastic Anaemia
- Enlarged (megaloblastic) erythropoiesis

The red blood cells in folate deficiency are:
Macrocytic
5) Folate and Neural Tube Defects
- fetal growth characterised by widespread cell division
- adequate folate is critical for DNA and RNA
- Neural tube defects arise from failure of embryonic neural tube closure 21-27 days post-conception when most women unaware of pregnancy
.
Folate deficiency at conception can cause birth defects of brain, spine, spinal cord:
- Anencephaly (stillborn); Encephalocoele; Spina bifida
- no cure; birth defects are permenant
.
- prevention: folic acid

Neural Tube Defects
DIAGRAM ON SLIDE 56 (not assessed)

6) Iron Overload
- increased total body iron stores
CAUSES:
- primary: genetic haemochromatosis (HFE gene)
- ineffective erythropoiesis with increased iron absorption: thalassemia
- Repeated blood transfusions: 200-250mg iron/bag
.
Clincal features:
- Organ dysfunction from iron deposition
- Heart, endocrine system, liver
Iron Overload
- Iron Measuremnts;
- serum iron: increased
- Transferrin saturation: increased
- Ferritn: increased
.
Abnormal lvier and hormonal function
- Treatment:
- Genetic: regular venesection to reduce iron level
- Transfusion iron overload; iron chelation

SUMMARY
DIAGRAM ON SLIDE 59
